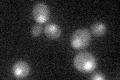
YML099C
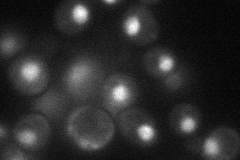
YML099C
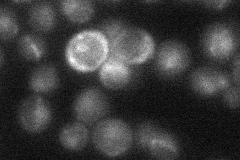
YML099C

View description
Zinc-finger transcription factor of the Zn(2)-Cys(6) binuclear cluster domain type, involved in the regulation of arginine-responsive genes; acts with Arg80p and Arg82p
Localization:
Intensity:
Fold change:
Significance:
-
C’ GFP library in SD
nucleus21.53 -
N' NOP1pr-GFP in SD
punctate,nucleus41.8519 -
N' TEF2pr-mCherry in SD

nucleus28.2579 -
N' NATIVEpr-GFP in SD
punctate,nucleus22.4067 -
N' TEF2pr-VC and Cyto-VN in SD

nucleus26.2753 -
C’ GFP library in SD+DTT

nucleus21.240.98No -
C’ GFP library in SD+H2O2

nucleus20.670.96No -
C’ GFP library in Starvation Media

nucleus17.070.79Yes -
C’ GFP library on the background of Pup2-DaMP

nucleus -
C’ GFP library on the background of CCT mutant

nucleus20.68330.960464No
